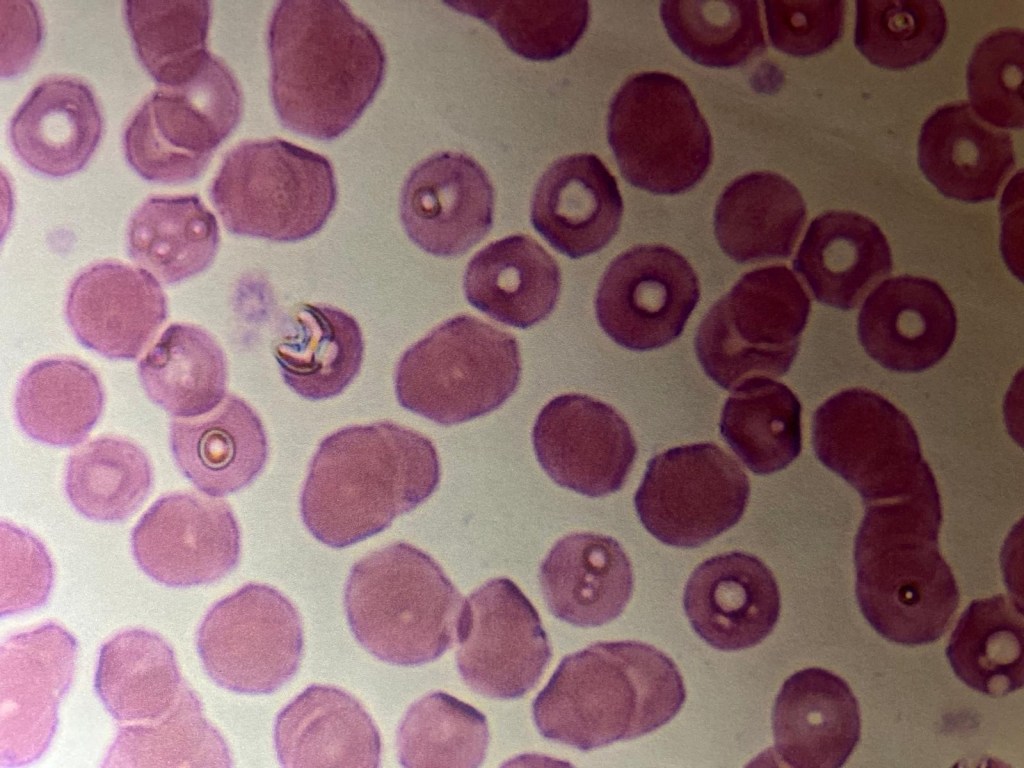

Salud y Vida
JAIME TORRES TORRES
Prensa Sin Censura
El Secretario de Salud Federal, Robert Kennedy Jr. retiró el respaldo millonario a las vacunas COVID por entender que no son seguras.
Aquí, sin embargo, el Departamento de Salud las sigue recomendando, cuando en semanas recientes la FDA dijo que PFIZER, Moderna y otras farmacéuticas deben clarificar en las etiquetas de los viales que inciden en daños al miocardio.
Prensa Sin Censura intentó sin éxito entrevistar ayer a la presidenta del Colegio de Tecnólogos Médicos de Puerto Rico, Bárbara Surillo y a la directora de la Secretaría Auxiliar para Regulación de la Salud Pública (SARSP), Wanda Rodríguez.
No respondieron y lo próximo será escribirles por email y correo regular exigiendo que permitan a Prensa Sin Censura acceso a información que se considera pública, amparados en el estatuto federal Freedom of Information Act (FOIA).
Mientras, adelantamos parte de las preguntas cuyas respuestas Prensa Sin Censura les exigirá en aras de salvaguardar la salud del Pueblo.
Preguntas
1) Si la sensitividad de una prueba determina la capacidad para detectar la posible enfermedad en casos donde un resultado sea positivo, ¿cómo es posible que al inicio y declaración de la emergencia de salud “mal llamada pandemia” hayan utilizado pruebas serológicas que lo que miden es la presencia de anticuerpos (inmunidad)
contrario a lo que se pretende detectar (virulencia)?
2) ¿De dónde los laboratorios en general y mayormente de comunidad obtuvieron para los pacientes controles positivos y controles negativos para aún asi validar esas pruebas serológicas al inicio de la “pandemia”?
3) Los anticuerpos detectados son IgM y el IgG, pero acaso estos mismos anticuerpos ¿no son detectados en otras múltiples condiciones? Entonces, ¿cómo se los adjudicaron al Covid-19?
4) ¿Realmente eran estas pruebas de uso diagnóstico para emitir un resultado de confiabilidad y crear, declarar y emitir un estado de emergencia por causa de un verdadero agente infeccioso?
5) ¿Por qué retiraron el uso de esas pruebas serológicas? [Las mismas que fueron objeto de las vistas celebradas por la comisión de salud en la Cámara de Representantes bajo la presidencia del legislador Juan Oscar Morales, el mismo que hoy preside la comisión de salud pero ahora en el Senado?
6) ¿Se debió su retiro a que no tenían propósitos diagnósticos o añadimos también que las sobrepagaron a razón de $38 dólares cada una a una compañía de contratistas que de salud nada sabían? [De hecho creo que todos deberíamos saber si ese dinero fue devuelto pues ni las pruebas debieron haberse utilizado nunca y menos haber pagado $38 millones pues compraron 1 milloncito]
7) ¿Podría este legislador -Juan Oscar Morales- presentar al Pueblo el estudio de validación realizado por las agencias pertinentes de esas mismas pruebas serológicas ya que durante las vistas ese fue uno de los argumentos mencionados y el mismo es el que determinaría si se podían usar o NO para declarar la emergencia ya que las pruebas moleculares con las que se contaba NO eran suficientes en ese momento?
8) Al retiro de las serológicas y comienzo de las pruebas de antígenos (clasificadas como waived test o que no requieren de un proceso riguroso de manejo ni de control de calidad, por lo que cualquiera las podía coger y realizar sólo con un simple adiestramiento), ¿cómo se explica que éstas pruebas contaban con una alta sensitividad, especificidad, precisión, exactitud y reproducibilidad si en multiples ocasiones las personas daban positivo en la mañana y al repetírsela en la tarde o al día siguiente daban negativo?
9) ¿Por qué no le entregaban al paciente la hoja del manufacturero “Fact Sheet For Patients” cuando le realizaban la prueba? [En ella está claramente la explicación de los posibles casos y causas de resultados falsos “negativos” y falsos “positivos”, además de las recomendaciones de manejo de caso con su proveedor de salud (médicos) y otros aspectos a considerar como lo es y tan importante que su aprobación es sólo EUA. (Autorización de Uso en Emergencia) y acaso eso no pasó ya?
10) Y si hablamos de las moleculares la pregunta es: ¿Se extrae la muestra que se toma nasofaringe u orofarige? ¿Eso es un procedimiento invasivo? ¿Cualquiera podía coger una muestra de esa naturaleza? ¿Con esa muestra que se extrae vendrá material genético de la misma persona? ¿Cómo se puede hacer una diferenciación de ese material? Si se amplifica y luego se determina material alguno, ¿cuántos ciclos se emplearon en ese análisis? Aquí en PR se permitió al principio el uso de “pool test” o sea varias muestras se analizaban a la vez por la falta de suficientes reactivos o volumen de muestras. ¿Qué garantía hay de que todos los positivos declarados no fueran “falsos positivos”?
11) ¿Por qué si usted daba positivo no le medían su carga viral para saber cuán virulento era su estado?
12) ¿Cómo se explica que en un núcleo familiar de 4 uno diera positivo y 3 no? ¿No nos dijeron que esto era algo muy virulento y sumamente infeccioso?

13) ¿Por qué si usted daba positivo a cualquiera de las pruebas utilizadas durante la “emergencia” le decían tienes COVID? Acaso, ¿eso no es un diagnóstico y el único que se supone que diagnostica es el médico?
14) Basado en la premisa anterior, ¿por qué le decían “quédate en tu casa” y ni a la oficina del médico podían ir? Entonces, ¿quién cura y quién diagnostica?
15) Al día de hoy, ¿cuál es el medicamento que recetan los médicos si usted se hace la prueba y obtiene un resultado positivo?
16) Hoy han transcurrido más de 5 años de esta declaración de emergencia y aún siguen pidiendo esas pruebas que constan con un EUA. ¿Eso será hasta cuándo, si ya la emergencia se dió por terminada? [¿Por qué no utilizar pruebas como el CBC y una evaluación del médico para un diagnóstico preciso?
17) En el Departamento de Salud hay evidencia contundente de los hallazgos que una experimentada tecnóloga médica viene encontrando por aproximadamente 5 años en los fluidos corporales de pacientes. La pregunta es: ¿Por qué este asunto no es atendido con la importancia que amerita si se trata de la salud del Pueblo? ¿Sabrá el Departamento de Salud las repercusiones del daño y la etiología de estas extrañas estructuras y por eso no ha querido prestar atención a estos importantes hallazgos?
18) Ya es de conocimiento que estas estructuras las están viendo otros tecnólogos médicos, pero ¿por qué no las reportan al igual que está haciendo la tecnóloga médica Alba Castro?
19) Si la Oficina para la Reglamentación de Facilidades del Departamento de Salud tiene conocimiento de estos hallazgos extraños, ¿no creen que deberían exijirle a todos los tecnólogos médicos que reporten estos hallazgos a los médicos para que las personas puedan ser diagnosticadas y tratadas como merecen?
20) ¿Creen ustedes que estos hallazgos son normales y comunes?
21) ¿Será posible que aquí en Puerto Rico a nadie le preocupe ni le importe la salud del pueblo?
22) ¿Creen ustedes que el Colegio de Médicos y Cirujanos así como el Colegio de Tecnólogos Médicos, a quienes también se les dió conocimiento y se les compartieron fotos como pruebas de estos hallazgos, tengan responsabilidad directa de tal situación que muy probablemente esté afectando la salud y la calidad de vida de muchos pacientes?
23) ¿Consideran ustedes que las Comisiones de Salud, tanto de la Cámara de Representantes como del Senado y sus respectivos presidentes Gabriel Rodríguez Aguiló y Juan Oscar Morales, deban asumir una posición de mayor responsabilidad, compromiso genuino con el Pueblo y atender este asunto con carácter de urgencia ya que podría culminar en una crisis de salud pública? ¿Ambos cuerpos legislativos tienen pleno conocimiento de si esto representa un riesgo potencial para la salud?
Postdata
Si usted, apreciado lector de Prensa Sin Censura, cree que su vida tiene valor -porque sin salud no podrá disfrutar de nada- y tal vez no tenga los recursos para luego sufragar costosos tratamientos, exija que por lo menos sus reclamos sean escuchados, valorados y atendidos. De esa manera, habrá cumplido con su conciencia de haber hecho lo propio por usted, por su vida y por su salud.
Teléfonos a llamar
Comisión de Salud Cámara de Representantes – 787-721-6040
Comisión de Salud Senado de Puerto Rico – 787-724-2030
Colegio de Tecnólogos Médicos de Puerto Rico – 787-792-6400
Secretaría Auxiliar para Regulación de la Salud Pública Depto de Salud – 787-765-2929
Colegio Médicos Cirujanos de Puerto Rico – 787-751-5979



Me gustaLe gusta a 1 persona